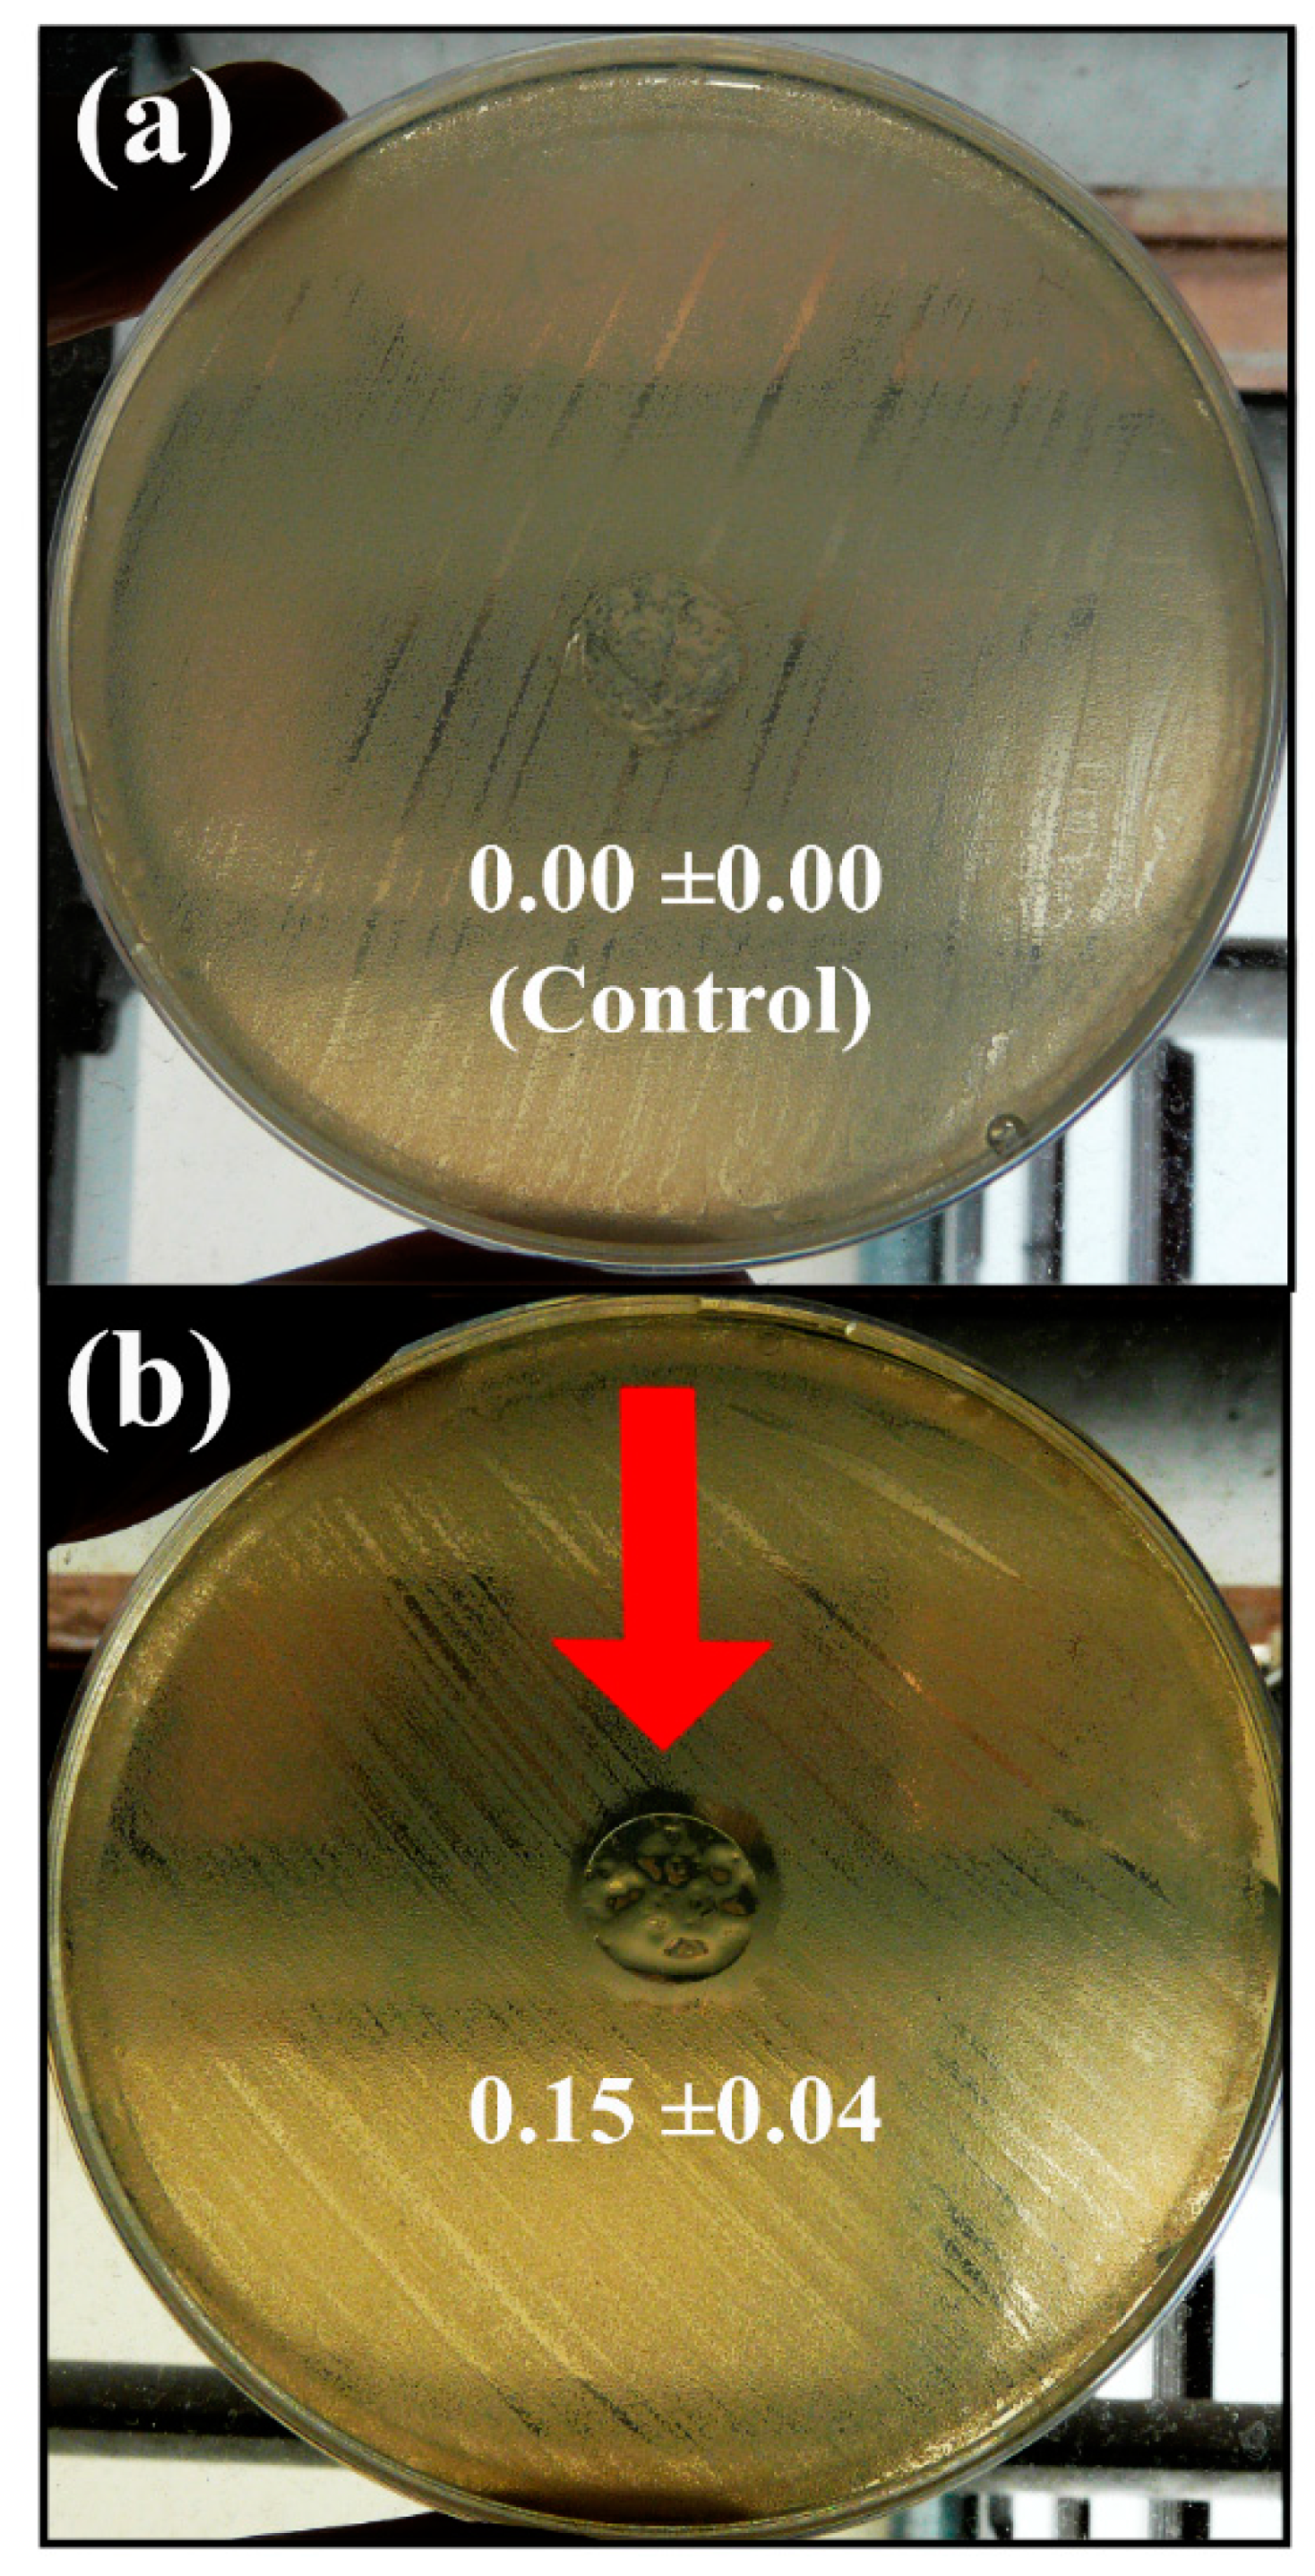
Polymers 11 00453 g005 Polymers 11 00453 g005

Carbon Nanofibers in Pure Form and in Calcium Alginate Composites Films: New Cost-Effective Antibacterial Biomaterials against the Life-Threatening Multidrug-Resistant Staphylococcus epidermidis
Abstract
1. Introduction
2. Materials and Methods
2.1. Materials
2.2. Synthesis of Calcium Alginate/CNFs Composite Films
2.3. Antibacterial Tests
2.3.1. Antibacterial Test for CNFs
2.3.2. Antibacterial Test for Calcium Alginate/CNFs Composite Film
2.4. Cytotoxicity Assays
2.4.1. Cytotoxicity Assay for CNFs
2.4.2. Cytotoxicity Assay for Calcium Alginate/CNFs Composite Film Extracts
2.5. Electron Microscopy
2.6. Raman Spectroscopy
2.7. Statistical Analysis
3. Results and Discussion
3.1. Morphology and Raman spectroscopy
3.2. Antibacterial Tests
3.3. Cytotoxicity Tests
4. Conclusions
Author Contributions
Funding
Acknowledgments
Conflicts of Interest
References
- WHO|High Levels of Antibiotic Resistance Found Worldwide, New Data Shows. Available online: http://www.who.int/mediacentre/news/releases/2018/antibiotic-resistance-found/en/ (accessed on 7 March 2019).
- Martí, M.; Frígols, B.; Serrano-Aroca, Á. Antimicrobial Characterization of Advanced Materials for Bioengineering Applications. J. Vis. Exp. 2018, e57710. [Google Scholar] [CrossRef] [PubMed]
- Ng, V.W.L.; Chan, J.M.W.; Sardon, H.; Ono, R.J.; García, J.M.; Yang, Y.Y.; Hedrick, J.L. Antimicrobial hydrogels: A new weapon in the arsenal against multidrug-resistant infections. Adv. Drug Deliv. Rev. 2014, 78, 46–62. [Google Scholar] [CrossRef] [PubMed]
- Chen, X.; Schluesener, H.J. Nanosilver: A nanoproduct in medical application. Toxicol. Lett. 2008, 176, 1–12. [Google Scholar] [CrossRef] [PubMed]
- Ahamed, M.; AlSalhi, M.S.; Siddiqui, M.K.J. Silver nanoparticle applications and human health. Clin. Chim. Acta 2010, 411, 1841–1848. [Google Scholar] [CrossRef] [PubMed]
- Hegstad, K.; Langsrud, S.; Lunestad, B.T.; Scheie, A.A.; Sunde, M.; Yazdankhah, S.P. Does the Wide Use of Quaternary Ammonium Compounds Enhance the Selection and Spread of Antimicrobial Resistance and Thus Threaten Our Health? Microb. Drug Resist. 2010, 16, 91–104. [Google Scholar] [CrossRef] [PubMed]
- McLean, D.T.F.; Lundy, F.T.; Timson, D.J. IQ-motif peptides as novel anti-microbial agents. Biochimie 2013, 95, 875–880. [Google Scholar] [CrossRef] [PubMed]
- Chongsiriwatana, N.P.; Patch, J.A.; Czyzewski, A.M.; Dohm, M.T.; Ivankin, A.; Gidalevitz, D.; Zuckermann, R.N.; Barron, A.E. Peptoids that mimic the structure, function, and mechanism of helical antimicrobial peptides. Proc. Natl. Acad. Sci. USA 2008, 105, 2794–2799. [Google Scholar] [CrossRef] [PubMed]
- Chen, Y.; Mant, C.T.; Farmer, S.W.; Hancock, R.E.W.; Vasil, M.L.; Hodges, R.S. Rational design of alpha-helical antimicrobial peptides with enhanced activities and specificity/therapeutic index. J. Biol. Chem. 2005, 280, 12316–12329. [Google Scholar] [CrossRef] [PubMed]
- Porter, E.A.; Wang, X.; Lee, H.S.; Weisblum, B.; Gellman, S.H. Non-haemolytic beta-amino-acid oligomers. Nature 2000, 404, 565. [Google Scholar] [CrossRef] [PubMed]
- Pelgrift, R.Y.; Friedman, A.J. Nanotechnology as a therapeutic tool to combat microbial resistance. Adv. Drug Deliv. Rev. 2013, 65, 1803–1815. [Google Scholar] [CrossRef] [PubMed]
- Seil, J.T.; Webster, T.J. Antimicrobial applications of nanotechnology: Methods and literature. Int. J. Nanomed. 2012, 7, 2767–2781. [Google Scholar]
- Yousefi, M.; Dadashpour, M.; Hejazi, M.; Hasanzadeh, M.; Behnam, B.; de la Guardia, M.; Shadjou, N.; Mokhtarzadeh, A. Anti-bacterial activity of graphene oxide as a new weapon nanomaterial to combat multidrug-resistance bacteria. Mater. Sci. Eng. C 2017, 74, 568–581. [Google Scholar] [CrossRef] [PubMed]
- Lara, H.H.; Garza-Treviño, E.N.; Ixtepan-Turrent, L.; Singh, D.K. Silver nanoparticles are broad-spectrum bactericidal and virucidal compounds. J. Nanobiotechnol. 2011, 9, 30. [Google Scholar] [CrossRef] [PubMed]
- Rai, M.; Ingle, A.P.; Pandit, R.; Paralikar, P.; Gupta, I.; Chaud, M.V.; dos Santos, C.A. Broadening the spectrum of small-molecule antibacterials by metallic nanoparticles to overcome microbial resistance. Int. J. Pharm. 2017, 532, 139–148. [Google Scholar] [CrossRef] [PubMed]
- Hu, W.; Peng, C.; Luo, W.; Lv, M.; Li, X.; Li, D.; Huang, Q.; Fan, C. Graphene-based antibacterial paper. ACS Nano 2010, 4, 4317–4323. [Google Scholar] [CrossRef] [PubMed]
- Martí, M.; Frígols, B.; Salesa, B.; Serrano-Aroca, Á. Calcium alginate/graphene oxide films: Reinforced composites able to prevent Staphylococcus aureus and methicillin-resistant Staphylococcus epidermidis infections with no cytotoxicity for human keratinocyte HaCaT cells. Eur. Polym. J. 2018, in press. [Google Scholar] [CrossRef]
- De Faria, A.F.; Martinez, D.S.T.; Meira, S.M.M.; de Moraes, A.C.M.; Brandelli, A.; Filho, A.G.S.; Alves, O.L. Anti-adhesion and antibacterial activity of silver nanoparticles supported on graphene oxide sheets. Colloids Surf. B Biointerfaces 2014, 113, 115–124. [Google Scholar] [CrossRef] [PubMed]
- Ruiz, O.N.; Fernando, K.A.S.; Wang, B.; Brown, N.A.; Luo, P.G.; McNamara, N.D.; Vangsness, M.; Sun, Y.P.; Bunker, C.E. Graphene oxide: A nonspecific enhancer of cellular growth. ACS Nano 2011, 5, 8100–8107. [Google Scholar] [CrossRef] [PubMed]
- Vallabani, N.V.S.; Mittal, S.; Shukla, R.K.; Pandey, A.K.; Dhakate, S.R.; Pasricha, R.; Dhawan, A. Toxicity of graphene in normal human lung cells (BEAS-2B). J. Biomed. Nanotechnol. 2011, 7, 106–107. [Google Scholar] [CrossRef] [PubMed]
- Zhang, W.; Yan, L.; Li, M.; Zhao, R.; Yang, X.; Ji, T.; Gu, Z.; Yin, J.J.; Gao, X.; Nie, G. Deciphering the underlying mechanisms of oxidation-state dependent cytotoxicity of graphene oxide on mammalian cells. Toxicol. Lett. 2015, 237, 61–71. [Google Scholar] [CrossRef] [PubMed]
- Stout, D.A.; Basu, B.; Webster, T.J. Poly(lactic-co-glycolic acid): Carbon nanofiber composites for myocardial tissue engineering applications. Acta Biomater. 2011, 7, 3101–3112. [Google Scholar] [CrossRef] [PubMed]
- Rivera-Briso, A.L.; Serrano-Aroca, Á. Poly(3-Hydroxybutyrate-co-3-Hydroxyvalerate): Enhancement strategies for advanced applications. Polymers 2018, 10, 732. [Google Scholar] [CrossRef]
- Baker, R.T.K. Catalytic growth of carbon filaments. Carbon N. Y. 1989, 27, 315–323. [Google Scholar] [CrossRef]
- Gardea, F.; Naraghi, M.; Lagoudas, D. Effect of thermal interface on heat flow in carbon nanofiber composites. ACS Appl. Mater. Interfaces 2014, 6, 1061–1072. [Google Scholar] [CrossRef] [PubMed]
- Llorens-Gámez, M.; Serrano-Aroca, Á. Low-Cost Advanced Hydrogels of Calcium Alginate/Carbon Nanofibers with Enhanced Water Diffusion and Compression Properties. Polymers 2018, 10, 405. [Google Scholar] [CrossRef]
- Serrano-Aroca, Á.; Ruiz-Pividal, J.F.; Llorens-Gámez, M. Enhancement of water diffusion and compression performance of crosslinked alginate with a minuscule amount of graphene oxide. Sci. Rep. 2017, 7, 11684. [Google Scholar] [CrossRef] [PubMed]
- Serrano-Aroca, Á.; Iskandar, L.; Deb, S. Green synthetic routes to alginate-graphene oxide composite hydrogels with enhanced physical properties for bioengineering applications. Eur. Polym. J. 2018, 103, 198–206. [Google Scholar] [CrossRef]
- Serrano-Aroca, Á.; Deb, S. Synthesis of irregular graphene oxide tubes using green chemistry and their potential use as reinforcement materials for biomedical applications. PLoS ONE 2017, 12, e0185235. [Google Scholar] [CrossRef] [PubMed]
- Draget, K.; Skjåk-bræk, G.; Smidsrød, O. Alginic acid gels: The effect of alginate chemical composition and molecular weight. Carbohydr. Polym. 1994, 25, 31–38. [Google Scholar] [CrossRef]
- Zactiti, E.M.; Kieckbusch, T.G. Release of potassium sorbate from active films of sodium alginate crosslinked with calcium chloride. Packag. Technol. Sci. 2009, 22, 349–358. [Google Scholar] [CrossRef]
- Ratner, B.D.; Hoffman, A.S.; Schoen, F.J.; Lemons, J.E. Biomaterials Science: An Introduction to Materials in Medicine; Academic Press: Toronto, ON, Canada, 2012; ISBN 008087780X. [Google Scholar]
- He, J.; Li, R.; Sun, X.; Wang, W.; Hu, J.; Xie, H.; Yin, H.; He, J.; Li, R.; Sun, X.; et al. Effects of Calcium Alginate Submicroparticles on Seed Germination and Seedling Growth of Wheat (Triticum aestivum L.). Polymers 2018, 10, 1154. [Google Scholar] [CrossRef]
- Soto, E.; Kim, Y.S.; Lee, J.; Kornfeld, H.; Ostroff, G. Glucan particle encapsulated rifampicin for targeted delivery to macrophages. Polymers 2010, 2, 681–689. [Google Scholar] [CrossRef]
- Vauchel, P.; Kaas, R.; Arhaliass, A.; Baron, R.; Legrand, J. A New Process for Extracting Alginates from Laminaria digitata: Reactive Extrusion. Food Bioprocess Technol. 2008, 1, 297–300. [Google Scholar] [CrossRef]
- Stout, D.A.; Yoo, J.; Santiago-Miranda, A.N.; Webster, T.J. Mechanisms of greater cardiomyocyte functions on conductive nanoengineered composites for cardiovascular applications. Int. J. Nanomed. 2012, 7, 5653–5669. [Google Scholar] [CrossRef]
- Tran, P.A.; Zhang, L.; Webster, T.J. Carbon nanofibers and carbon nanotubes in regenerative medicine. Adv. Drug Deliv. Rev. 2009, 61, 1097–1114. [Google Scholar] [CrossRef] [PubMed]
- Ashfaq, M.; Verma, N.; Khan, S. Copper/zinc bimetal nanoparticles-dispersed carbon nanofibers: A novel potential antibiotic material. Mater. Sci. Eng. C 2016, 59, 938–947. [Google Scholar] [CrossRef] [PubMed]
- Song, K.; Wu, Q.; Zhang, Z.; Ren, S.; Lei, T.; Negulescu, I.I.; Zhang, Q. Porous Carbon Nanofibers from Electrospun Biomass Tar/Polyacrylonitrile/Silver Hybrids as Antimicrobial Materials. ACS Appl. Mater. Interfaces 2015, 7, 15108–15116. [Google Scholar] [CrossRef] [PubMed]
- Cooksey, D.A. Molecular mechanisms of copper resistance and accumulation in bacteria. FEMS Microbiol. Rev. 1994, 14, 381–386. [Google Scholar] [CrossRef] [PubMed]
- Li, X.Z.; Nikaido, H.; Williams, K.E. Silver-resistant mutants of Escherichia coli display active efflux of Ag+ and are deficient in porins. J. Bacteriol. 1997, 179, 6127–6132. [Google Scholar] [CrossRef] [PubMed]
- Wade, K.C.; Benjamin, D.K. Clinical Pharmacology of Anti-Infective Drugs. In Infectious Diseases of the Fetus and Newborn Infant; Elsevier: Amsterdam, Netherlands, 2011; pp. 1160–1211. [Google Scholar]
- Lee, J.Y.H.; Monk, I.R.; Gonçalves da Silva, A.; Seemann, T.; Chua, K.Y.L.; Kearns, A.; Hill, R.; Woodford, N.; Bartels, M.D.; Strommenger, B.; et al. Global spread of three multidrug-resistant lineages of Staphylococcus epidermidis. Nat. Microbiol. 2018, 3, 1175–1185. [Google Scholar] [CrossRef] [PubMed]
- Speziale, P.; Geoghegan, J.A. Biofilm formation by staphylococci and streptococci: Structural, functional and regulatory aspects and implications for pathogenesis. Front. Cell. Infect. Microbiol. 2015, 5, 31. [Google Scholar] [CrossRef] [PubMed]
- Christensen, G.D.; Bisno, A.L.; Parisi, J.T.; McLaughlin, B.; Hester, M.G.; Luther, R.W. Nosocomial septicemia due to multiply antibiotic-resistant Staphylococcus epidermidis. Ann. Intern. Med. 1982, 96, 1–10. [Google Scholar] [CrossRef] [PubMed]
- Liu, S.; Zeng, T.H.; Hofmann, M.; Burcombe, E.; Wei, J.; Jiang, R.; Chen, Y. Antibacterial activity of graphite, graphite oxide, graphene oxide, and reduced graphene oxide: Membrane and oxidative stress. ACS Nano 2011, 5, 6971–6980. [Google Scholar] [CrossRef] [PubMed]
- Yakoob, J.; Naz, S.; Awan, S.; Abbas, Z.; Jafri, W.; Hamid, S.; Jafri, F.; Usman, M.W. Comparison of Antimicrobial Activity of Zinc Chloride and Bismuth Subsalicylate Against Clinical Isolates of Helicobacter pylori. Microb. Drug Resist. 2013, 20, 305–309. [Google Scholar] [CrossRef] [PubMed]
- Usman, A.; Hussain, Z.; Riaz, A.; Khan, A.N. Enhanced mechanical, thermal and antimicrobial properties of poly(vinyl alcohol)/graphene oxide/starch/silver nanocomposites films. Carbohydr. Polym. 2016, 153, 592–599. [Google Scholar] [CrossRef] [PubMed]
- Straccia, M.C.; Romano, I.; Oliva, A.; Santagata, G.; Laurienzo, P. Crosslinker effects on functional properties of alginate/N-succinylchitosan based hydrogels. Carbohydr. Polym. 2014, 108, 321–330. [Google Scholar] [CrossRef] [PubMed]
- Zefirov, Y.V.; Zorky, P.M. New applications of van der Waals radii in chemistry. Russ. Chem. Rev. 1995, 64, 415. [Google Scholar] [CrossRef]
- Chaba, J.M.; Nomngongo, P.N. Preparation of V2O5-ZnO coated carbon nanofibers: Application for removal of selected antibiotics in environmental matrices. J. Water Process Eng. 2018, 23, 50–60. [Google Scholar] [CrossRef]
- Liu, Y.; Pan, C.; Wang, J. Raman spectra of carbon nanotubes and nanofibers prepared by ethanol flames. J. Mater. Sci. 2004, 39, 1091–1094. [Google Scholar] [CrossRef]
- Cançado, L.G.; Jorio, A.; Ferreira, E.H.M.; Stavale, F.; Achete, C.A.; Capaz, R.B.; Moutinho, M.V.O.; Lombardo, A.; Kulmala, T.S.; Ferrari, A.C. Quantifying defects in graphene via Raman spectroscopy at different excitation energies. Nano Lett. 2011, 11, 3190–3196. [Google Scholar] [CrossRef] [PubMed]
- Zou, X.; Zhang, L.; Wang, Z.; Luo, Y. Mechanisms of the Antimicrobial Activities of Graphene Materials. J. Am. Chem. Soc. 2016, 138, 2064–2077. [Google Scholar] [CrossRef] [PubMed]
- Tegou, E.; Magana, M.; Katsogridaki, A.E.; Ioannidis, A.; Raptis, V.; Jordan, S.; Chatzipanagiotou, S.; Chatzandroulis, S.; Ornelas, C.; Tegos, G.P. Terms of endearment: Bacteria meet graphene nanosurfaces. Biomaterials 2016, 89, 38–55. [Google Scholar] [CrossRef] [PubMed]

© 2019 by the authors. Licensee MDPI, Basel, Switzerland. This article is an open access article distributed under the terms and conditions of the Creative Commons Attribution (CC BY) license (http://creativecommons.org/licenses/by/4.0/).
Share and Cite
Salesa, B.; Martí, M.; Frígols, B.; Serrano-Aroca, Á. Carbon Nanofibers in Pure Form and in Calcium Alginate Composites Films: New Cost-Effective Antibacterial Biomaterials against the Life-Threatening Multidrug-Resistant Staphylococcus epidermidis. Polymers 2019, 11, 453. https://doi.org/10.3390/polym11030453
Salesa B, Martí M, Frígols B, Serrano-Aroca Á. Carbon Nanofibers in Pure Form and in Calcium Alginate Composites Films: New Cost-Effective Antibacterial Biomaterials against the Life-Threatening Multidrug-Resistant Staphylococcus epidermidis. Polymers. 2019; 11(3):453. https://doi.org/10.3390/polym11030453
Chicago/Turabian StyleSalesa, Beatriz, Miguel Martí, Belén Frígols, and Ángel Serrano-Aroca. 2019. "Carbon Nanofibers in Pure Form and in Calcium Alginate Composites Films: New Cost-Effective Antibacterial Biomaterials against the Life-Threatening Multidrug-Resistant Staphylococcus epidermidis" Polymers 11, no. 3: 453. https://doi.org/10.3390/polym11030453
APA StyleSalesa, B., Martí, M., Frígols, B., & Serrano-Aroca, Á. (2019). Carbon Nanofibers in Pure Form and in Calcium Alginate Composites Films: New Cost-Effective Antibacterial Biomaterials against the Life-Threatening Multidrug-Resistant Staphylococcus epidermidis. Polymers, 11(3), 453. https://doi.org/10.3390/polym11030453

